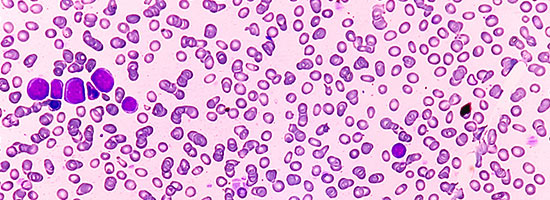

Advances in Motion provides health care professionals with information about the latest breakthroughs, research and clinical advances from Massachusetts General Hospital.
EXPLORE OUR SPECIALTIES BROWSE OUR TOPICS SUBSCRIBE TO RECEIVE UPDATES
Featured In Oncology
Pursuing a Gentler Path to Treat—and Potentially Cure—Acute Myeloid Leukemia
The PARADIGM study compared intensive induction chemotherapy (IC) to a novel combination therapy, azacitidine and venetoclax (aza-ven), in patients newly diagnosed with acute myeloid leukemia and eligible for IC. Results showed that aza-ven clearly outperformed IC in patients enrolled on study.
Featured In Cardiovascular
Simple New Noninvasive Exercise Measure Can Risk-Stratify Patients With Dyspnea on Exertion
Gregory D. Lewis, MD, and colleagues recommend measuring time to VO2 recovery of 12.5% after cardiopulmonary exercise testing of patients with dyspnea on exertion, showing that this metric closely reflects cardiac-specific performance and predicts heart failure outcomes.
Featured In Otolaryngology
From Implants to Editing: A New Era in Hearing Restoration
A study comparing gene therapy and cochlear implants found comparable or improved outcomes, while new research in mouse models highlights potential treatments for late-onset genetic deafness.
Featured In Endocrinology
Study Shows Higher Obesity Prevalence When Using Anthropometric Measurements
Massachusetts General Hospital research indicates that more Americans have obesity based on new obesity classification that uses BMI and anthropometric measurements.
Featured In Orthopaedics
A Next-Generation Approach for Managing Periprosthetic Joint Infection in Total Joint Arthroplasty
Orhun Muratoglu, PhD, Ebru Oral, PhD, and their team are developing a gentamicin-containing polyethylene material to deliver localized antibiotics for total joint replacements. Their goal is to reduce periprosthetic joint infections and improve the outcomes of two-stage revision surgeries, the current standard of care.
The Latest Oncology Advances
Neoadjuvant Chemotherapy for Advanced Ovarian Cancer Improves Short-term Survival Regardless of Hospital Case Volume
For patients with advanced ovarian cancer, high use of neoadjuvant chemotherapy improves 90-day surgical mortality at hospitals of all case volumes, but that outcome and 5-year survival are best for patients treated at high-volume centers with high use of neoadjuvant chemotherapy.
Monitoring of PSA Density Advised During Active Surveillance of Prostate Cancer
Adam S. Feldman, MD, MPH, Andrew Gusev, MD, and colleagues, are the first to show that prostate-specific antigen density retains significant prognostic value after diagnosis of prostate cancer, with values ≥0.15 ng/mL2 at any point during active surveillance nearly quadrupling the risk of biopsy grade progression.
Advances Specialties
Cardiovascular
Study Reveals Brain-Heart Connection in Depression and Anxiety
Investigators at Mass General Brigham found that stress-related brain activity may explain the increased risk of heart disease with depression and anxiety.
Neuroscience
Study Reveals Brain-Heart Connection in Depression and Anxiety
Investigators at Mass General Brigham found that stress-related brain activity may explain the increased risk of heart disease with depression and anxiety.
Orthopaedics
Emerging Treatment Offers Hope for Patients with Chronic Musculoskeletal Pain
Could a minimally invasive procedure ease chronic musculoskeletal pain? Yan Epelboym, MD, MPH, discusses the promise of trans-arterial embolization.
May 9, 2025
Conference: Midlife Women's Health 2025: A Multidisciplinary Approach to Care
The Midlife Women's Health 2025 course is led by a multidisciplinary group of experts from Massachusetts General Hospital who will present on the evaluation and management of osteoporosis, gastrointestinal malignancy, stress, obesity, substance use disorder, anxiety, sexual dysfunction, breast cancer, and menopausal hormone therapy to assist clinicians in caring for their midlife patients.
Brain mechanisms of vagus nerve stimulation and stress reduction training for migraine
The study involves multiple visits over 6 months. You will complete an 8-week stress reduction treatment that includes a medical device worn in the ear and attend MRI and PET scans. You will also complete daily migraine diaries online.
Multimodal profiling of stress-induced immune reprogramming in cardiovascular participants
The purpose of this research study is to learn about the effects of stress on the brain and disease of the heart and blood vessels (cardiovascular disease or CVD).